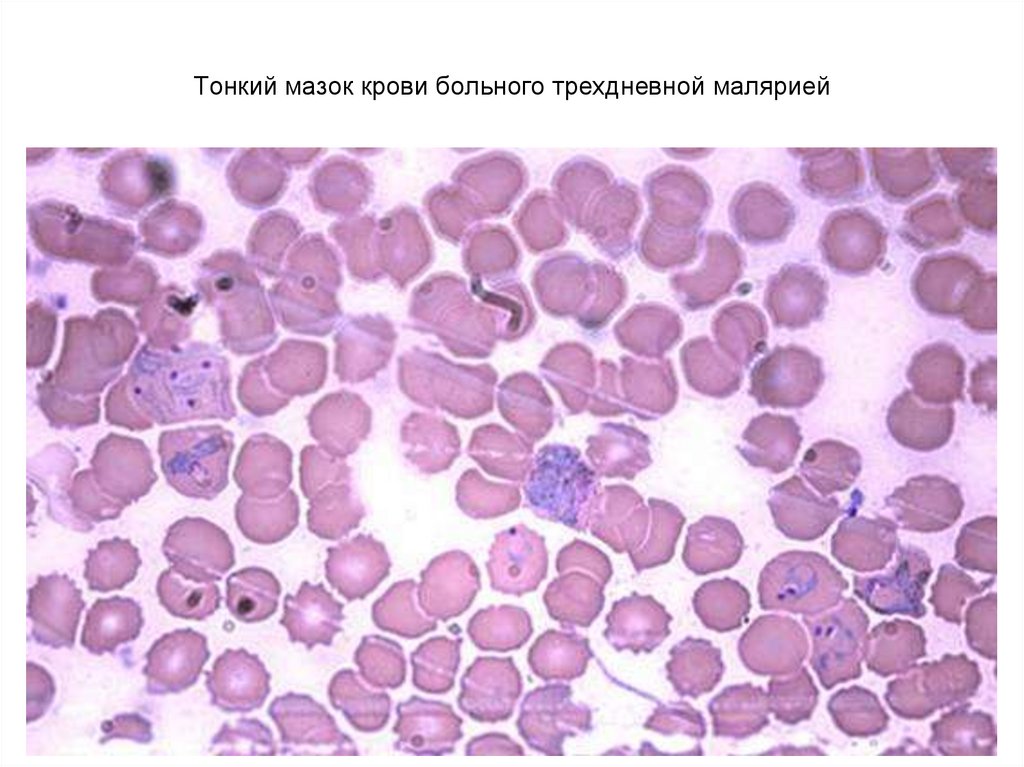

Похожие презентации:
Тип Простейшие (Protozoa) Простейшие – паразиты человека
1. ФГБОУ ВО СЗГМУ ИМ. И.И. МЕЧНИКОВА МИНЗДРАВА РОССИИ кафедра медицинской биологии Тип Простейшие (Protozoa) Простейшие – паразиты
человекаСамостоятельная работа
Авторы: проф. С.В. Костюкевич
доц. Н.Г. Перевозчикова
доц. В.С. Турицин
2016 г.
2. Инструкция к выполнению самостоятельной работы
1.Изучите теоретический материал по теме «Простейшие»,
используя:
Учебник «Биология» / Под реакцией В.Н. Ярыгина.
Учебное пособие «Введение в медицинскую паразитологию».
1.
В учебном пособии «Введение в медицинскую
паразитологию» выполните тестовые задания по теме
«Простейшие» (отметьте правильные ответы).
2.
В рабочей тетради зарисуйте микропрепараты и решите
учебно-ситуационные задачи по теме «Простейшие» (тема
№16).
3.
ТИП ПРОСТЕЙШИЕ (PROTOZOA)Характеристика:1. Микроскопические размеры. 2. Одноклеточные.
3. Наличие органоидов общего и специального значения.
4. Способность к образованию цист.
Класс Саркодовые
(SARCODINA)
Класс Жгутиковые
(FLAGELLATA)
Класс Инфузории
(INFUSORIA)
Класс Споровики
(SPOROZOA)
4.
1.Класс Саркодовые (SARCODINA)
Общая характеристика:
Непостоянная форма тела 2. Псевдоподии
Большинство Саркодовых – свободноживущее виды.
Например, раковинная амеба.
Среди саркодовых встречаются паразиты человека.
Представители:
Дизентерийная амеба (Entamoeba histolytica)
Амебы группы Limax (Acanthamoeba, Naegleria)
5.
Дизентерийная амеба (Entamoeba histolytica) –паразит человека, вызывающий кишечный амебиаз.
Жизненные формы дизентерийной амеба (Entamoeba histolytica)
Дизентерийная амеба (Entamoeba histolytica).
А – малая вегетативная форма (forma minuta);
Б – циста;
В - большая вегетативная или тканевая форма - (forma magna). 1 – ядро;
2 – цитоплазма; 3 – фагоцитированные бактерии. 4 – гликогеновые гранулы;
5 – фагоцитированные эритроциты.
6.
Жизненный циклдизентерийной
амебы (Entamoeba
histolytica)
ПЕЧЕНЬ
абсцесс
Погибают в
окружающей среде
7. Малая вегетативная (просветная) форма Entamoeba histolytica живет в просвете толстой кишки и питается бактериями
8.
Зарисуйте в рабочую тетрадь!3
5
Дизентерийная амеба Entamoeba histolytica,
f. magna (мазок фекалий)
(об.90).
1 - ядро;
2 - ядрышко;
3 - эктоплазма;
4 - эндоплазма;
2
1
4
5 - вакуоли с
фагоцитированными
эритроцитами.
9. Цисты Entamoeba histolytica имеют 4 ядра
Зарисуйте в рабочую тетрадь!Цисты Entamoeba histolytica имеют 4 ядра
Циста дизентерийной
амебы (мазок фекалий)
(об. 90).
1 - 4 ядра;
2 - оболочка.
10. Большая вегетативная форма Entamoeba histolytica с фагоцитированными эритроцитами
11. Амебы группы Limax (Acanthamoeba, Naegleria) Факультативный паразит, может жить и размножаться в воде. Вызывает амебный
менингоэнцефалит, кератит,поражения кожи
12. Амебы группы Лимакс (Акантамеба)
ТрофозоитЦиста
13.
Класс Жгутиковые (FLAGELLATA)Общая характеристика класса:
1. Постоянная форма тела
2. Наличие жгутиков
3. Наличие ундулирующей мембраны ( у некоторых
представителей)
Представители паразитов человека:
Трипаносомы (Trypanosoma brucei,Trypanosoma cruzi)
Лейшмании (Leishmania donovani, Leishmania tropica)
Лямблия (Lamblia intestinalis)
Урогенитальная трихомонада (Trichomonas vaginalis)
14.
Трипаносомы (Trypanosoma) – возбудители заболеванийчеловека и животных.
У человека паразитируют несколько видов трипаносом. Среди них:
Trypanosoma brucei, вызывающая африканский трипаносомоз
(сонная болезнь). Переносчик – Муха це-це
Trypanosoma cruzi Американский трипаносомоз (болезнь Чагаса).
Переносчик - Триатомовый (поцелуйный) клоп
Тrypanosoma в крови
15. Характерные пассивные движения эритроцитов при трипаносомозе
16. Муха це-це – переносчик возбудителей африканского трипаносомоза
Триатомовый (поцелуйный)клоп – переносчик
возбудителей американского
трипаносомоза (болезни
Чагаса).
17.
Зарисуйте в рабочую тетрадь!Трипаносома - Trypanosoma brucei
(мазок крови) (об.90).
1 – ядро трипаносомы;
2
1
4
2 - ундулирующая
мембрана;
3 - свободная часть
жгутика;
4 - эритроциты.
3
18. Терминальная стадия сонной болезни.
Фотография из архива акад. Е.Н.Павловского19.
Лейшмании (Leishmania)Внутриклеточные паразиты человека и многих млекопитающих.
Возбудители кожных и висцеральных лейшманиозов, распространенных в
странах Европы, Азии, Африки и Америки.
Специфические переносчики – москиты.
У человека могут паразитировать несколько видов лейшманий. Среди них:
Leishmania donovani - возбудитель висцерального лейшманиоза
Leishmania tropica - возбудитель кожного лейшманиоза
Москит Phlebotomus–
специфический переносчик
лейшманий.
20. Схема трансмиссивной передачи возбудителя кожного лейшманиоза
ПереносчикмоскитСлюнные железы москита
Отделяемое кожных язв
позвоночный
хозяин
21.
Кожныйлейшманиоз
(пендинская
язва).
Возбудитель
– Leishmania
tropica.
22.
Фотографии из архива акад. Е.Н.ПавловскогоВисцеральный лейшманиоз (Кала-азар). Возбудитель – Leishmania donovani.
Отмечены границы увеличенной печени и селезенки.
23.
Зарисуйте в рабочую тетрадь!4
3
2
1
Лейшмания - Leishmania tropica,
жгутиковая форма (культура)
(об.90).
1 - ядро;
2 - цитоплазма;
3 - кинетопласт;
4 - жгутик.
24.
Зарисуйте в рабочую тетрадь!2
Лейшмания - Leishmania
tropica,
безжгутиковая внутриклеточная форма
лейшмании
(отделяемое из язв) (об.90).
3
1
1 - клетка хозяина;
2 - ядро клетки хозяина;
3 - лейшмании.
25.
Лямблии(Lamblia intestinalis)
Паразитируют в тонкой кишке человека. Вызывают лямблиоз.
26. Движение трофозоита Lamblia intestinalis в содержимом толстой кишки
27. Трофозоиты Lamblia intestinalis между ворсинками тонкой кишки
ТрофозоитыLamblia intestinalis
28.
Зарисуйте в рабочую тетрадь!1
2
Лямблия - Lamblia intestinalis,
вегетативная стадия
(дуоденальное содержимое)
(об.90).
1 - два ядра;
2 - присасывательный диск;
3
4
3 - жгутики;
4 - аксонема.
29. Цисты лямблий в мазке фекалий
30. Трихомонада мочеполовая (Trichomonas vaginalis)
Паразитирует на слизистых оболочках мочеполовой системы человека,вызывая воспалительные процессы. Цист не образует. Трихомоноз
передается половым путем.
31. Trichomonas vaginalis в мазке из уретры
трихом киш.mpg32.
Класс Споровики (SPOROZOA)Общая характеристика класса:
1. Наличие органоидов проникновения
2. Половое и бесполое размножение
Все представители класса являются паразитами.
У человека паразитируют множество видов споровиков, наибольшее
значение для медицины имеют:
Малярийные плазмодии
Токсоплазма
33. МАЛЯРИЯ
Малярийные плазмодии – паразиты человека:1) P. vivax – возбудитель 3-х дневной малярии
2) P. malariae - возбудитель 4-х дневной малярии
3) P. Falciparum – возбудитель тропической малярии
4) P. ovale - возбудитель малярии типа 3-х дневной
Самка комара рода
Anopheles –
специфический
переносчик
возбудителей малярии
34. Динамика завозных случаев малярии в Россию
900800
700
600
Из бывших союзных
республик
500
400
Из стран дальнего
зарубежья
300
200
100
20
03
20
01
19
99
19
97
19
95
19
93
19
91
19
89
0
35.
Слюнныежелезы комара
комар
Цикл развития малярийного плазмодия
человек
Печень человека
36. Шизонт малярийного плазмодия в печени человека (отмечен стрелкой)
37. Гепатоспленомегалия при малярии
Кровоизлияния в мозг при тропическоймалярии
38. Тонкий мазок крови больного трехдневной малярией
39.
Зарисуйте в рабочую тетрадь!Малярийный плазмодий - Plasmodium vivax (мазок крови) (об.90).
3
1
2
2
1
3
Г
А - Кольцевидный
(юный)
трофозоит:
1 - ядро;
2 - вакуоль;
3 - цитоплазма.
Г - Неповрежденный
эритроцит.
Б - Амебовидный
(взрослый)
трофозоит:
1 - ядро;
2 - цитоплазма с
глыбками меланина;
3 - псевдоподии.
1
2
В - Многоядерный
плазмодий (шизонт):
1 - ядра;
2 - цитоплазма.
40. Токсоплазма (Toxoplasma gondii)
Поражает широкий круг хозяев из типа Хордовых и локализуется вразличных тканях.
Скопление токсоплазм внутри
клетки хозяина.
Компьютерная томография головного
мозга при церебральном токсоплазмозе.
41. Цикл развития токсоплазмы
Промежуточные хозяеваОкончательный хозяин
!!!
ооцисты
42. Токсоплазма -Toxoplasma gondii (трофозоиты в перитонеальном экссудате мыши) (об.90). 1 - ядро; 2 - цитоплазма; 3 - клетки
Зарисуйте в рабочую тетрадь!3
1
Токсоплазма -Toxoplasma
gondii
(трофозоиты в
перитонеальном экссудате
мыши) (об.90).
1 - ядро;
2 - цитоплазма;
2
3 - клетки хозяина.
43. Трофозоиты балантидия в кишечном содержимом
Класс Инфузории (INFUSORIA)Характеристика класса:
1. Реснички. 2. Ядерный диморфизм. 3. Бесполое и половое (конъюгация)
размножение
Единственной паразитической инфузорией человека является Балантидий
(Balantidium coli). Паразитирует в толстой кишке человека, иногда проникает в
стенку кишечника, вызывая образование язв.
Трофозоиты
балантидия
в кишечном содержимом
44. Движение трофозоита Balantidium coli в кишечном содержимом
45. Балантидии стенке толстой кишки (указаны стрелками)
46. Трофозоиты (вегетативные стадии) Balantidium coli
Циста Balantidium coli47.
Зарисуйте в рабочую тетрадь!1
Балантидий Balantidium coli,
вегетативная
стадия
(мазок фекалий)
(об.40.).
2
3
1 - цитостом;
2 - макронуклеус;
3 - микронуклеус.

Медицина
Медицина








